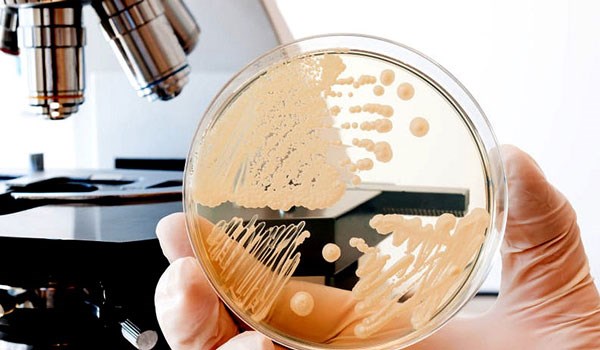

Στρεπτόκοκκος: Ανησυχία για τα κρούσματα στα σχολεία – Ποια θα είναι κλειστά σήμερα
Στην Καλαμαριά Θεσσαλονίκης, κλειστό θα παραμείνει το σχολικό συγκρότημα στην Πλατεία Σκρα, στο οποίο στεγάζονται το 5ο και το 13ο Δημοτικό Σχολείο, καθώς και το 27ο Νηπιαγωγείο. Κλειστό θα είναι και το Κλειστό Γυμναστήριο του συγκροτήματος. Επίσης, δεν θα λειτουργήσουν το 2ο Δημοτικό Σχολείο και το 9ο Νηπιαγωγείο στην ίδια περιοχή.
Στο δήμο Δέλτα, μετά από τέσσερα περιστατικά που εντοπίστηκαν σε σχολεία των Κυμίνων και της Σίνδου, πραγματοποιούνται προληπτικές απολυμάνσεις, ενώ στον δήμο Ωραιοκάστρου, κρούσμα εντοπίστηκε στο 6ο Νηπιαγωγείο.
Στις Σέρρες, κλειστά θα παραμείνουν το 4ο και 17ο Δημοτικό Σχολείο, το 8ο και 25ο Δημοτικό Σχολείο, καθώς και το Μουσικό Σχολείο Σερρών.
Στην Αττική, τα 1ο και 5ο Νηπιαγωγεία Βύρωνα δεν θα λειτουργήσουν προληπτικά.
Τέλος, στην Κρήτη, δεν θα λειτουργήσει σήμερα το Νηπιαγωγείο Καστελλίου στον Δήμο Μινώα Πεδιάδας, ενώ κρούσματα έχουν εντοπιστεί και στο 2ο Νηπιαγωγείο Ατσιποπούλου Ρεθύμνου.
Σύμφωνα με τον ΕΟΔΥ ο στρεπτόκοκκος ομάδας Α μεταδίδεται μέσω:
Των μολυσμένων σταγονιδίων από τις εκκρίσεις ασθενών
Της επαφής με επιμολυσμένες επιφάνειες
Την επαφή με μολυσμένες δερματικές βλάβες ασθενών
Από υγιείς φορείς του βακτηρίου
Ο στρεπτόκοκκος ομάδας Α μεταδίδεται πολύ πιο εύκολα από άτομα που είναι συμπωματικά και νοσούν, παρά από υγιείς φορείς του βακτηρίου.